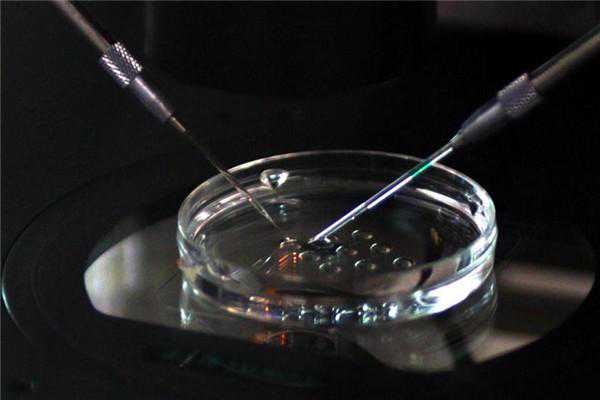

尽管试管婴儿技术很发达,使得很多不孕夫妻拥有了做父母的权利,但对于移植失败还是不可避免的。试管婴儿的成功率不是百分百,有的人一次试管就成功,有的人却多次失败,这到底是因为什么原因呢?
精卵的品质:精子的数目及活动力,能够决定受精卵的质量,但整体而言,男性精子的质量受年龄的影响相对较慢,到50、60岁的男性仍然有正常精子的比例不低,而吸烟、酗酒、糖尿病、肥胖、缺乏运动等因素对精子质量的影响更为明显!
卵子的质量:影响卵子质量最直接的因素是女性的年龄,女性的年龄越大,卵子品质就越差,超过35岁,卵子的品质开始明显老化、甚至出现直线下降的情况,相对应的试管成功率也会大打折扣。一般而言,如果以18-22岁年青女性卵子质量为100分的话,到35岁左右还有60-70分,到40-43岁可能就剩5-10分了,超过43岁就是5分以下了……
胚胎的品质是试管婴儿成功的重要因素,好的胚胎当然更容易成功,好的胚胎来自于好的精卵结合以及稳定的实验室培养系统
胚胎植入术,是试管婴儿成功的重要条件之一,适当的将胚胎放在更容易着床的位置,很容易增加成功率,这与生殖中心医生的经验和技术直接相关。
子宫内膜的品质:子宫内膜是胚胎着床的地方,子宫内膜如果厚度适当,血流丰富且细胞分裂良好,相当于肥沃疏松的土壤,会增加胚胎着床率,反之,若子宫内膜太薄,血流量不足,荷尔蒙分泌缺乏,这种内膜就相当于盐碱地,胚胎就不易着床。另外在植入胚胎的时候,子宫会有收缩的动作,有时候胚胎甚至会被推到输卵管,造成子宫外孕,所以胚胎植入后要有充分的卧床休息,补充足够的黄体素,以增加着床率减少外孕的比率
在做试管婴儿的整个过程中,有以下几个方面会导致试管婴儿的失败:

促排卵失败;年龄偏大的女性,卵巢储备差,卵泡少质量差。卵巢早衰的女性,先天储备少,也很容易失败,另外患有多囊卵巢综合征的女性,由于卵泡发育异常,促排卵比较困难,容易发生卵巢过度刺激
取卵失败;女性促排卵后有一定数量的卵泡,但卵母细胞没有成功取出。选择技术先进的医疗机构,是可以降低或者避免取卵失败的情况
胚胎质量不合格;最新的试管婴儿技术可以在陪同移植前检测胚胎质量,如果受精卵不好或形成的胚胎质量不好,都会导致失败,也不能用不合格的胚胎进行移植
受孕失败;胚胎移植后,等待母体受孕,如果胚胎质量差、子宫内环境差等原因也不适合胚胎的着床和发育
目前,第三代试管婴儿技术,可以挑选优质胚胎进行移植,提高妊娠率和降低流产率,从最大程度避免反复失败的情况,不过目前国内只允许特定的夫妻才可以选择试管婴儿,对第三代试管婴儿技术的使用管的比较严,可选择赴美国、欧洲、泰国等第三代试管婴儿技术成熟、先进,也相对自由的地区,进行第三代试管婴儿,提升受孕成功率。
